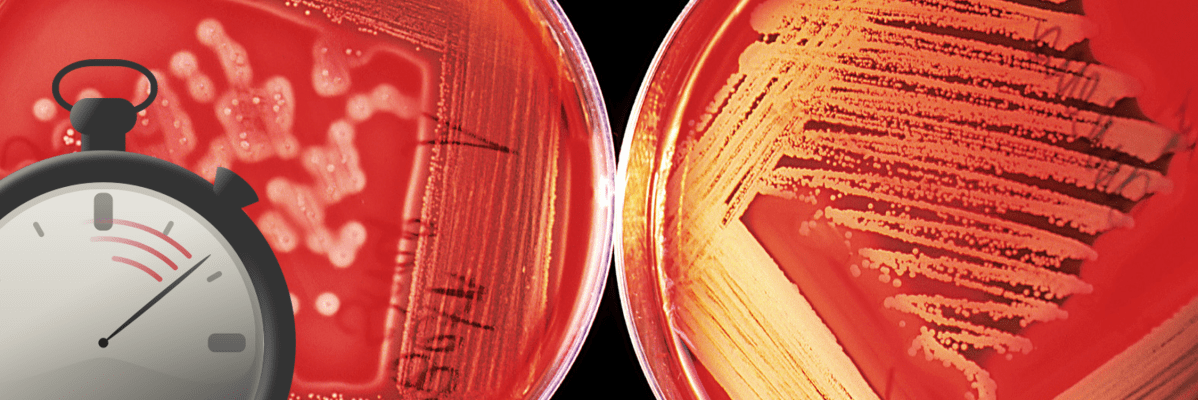
Blood Cultures Before Antibiotics&nbsp;Matter

Tag: antibiotics
Antibiotic Effects on Oral Contraceptives
Today’s pearl addresses a misconception regarding a drug interaction between oral contraceptives and antibiotics.
Are back-up methods of contraception required? Does this apply to all antibiotics?
Continue reading “Antibiotic Effects on Oral Contraceptives”Ceftriaxone and Lactated Ringer Compatibility
Today’s pearl addresses the safety of ceftriaxone administration in a patient also ordered for lactated ringers.
Will this precipitate any problems?
Continue reading “Ceftriaxone and Lactated Ringer Compatibility”Blood Cultures Before Antibiotics Matter
Today’s pearl is why it is important to obtain blood cultures prior to antibiotic administration whenever possible.
The difference a few minutes can make.
Continue reading “Blood Cultures Before Antibiotics Matter”Black Box Drugs We Use – Fluoroquinolones
Today’s pearl is why I think fluoroquinolones should be relegated to second or third-line therapy for most infections.
And should be renamed “fluoroquino-leave-them-alones”
Continue reading “Black Box Drugs We Use – Fluoroquinolones”The New Community-Acquired Pneumonia Guidelines are Finally Here!
Today’s pearl is a brief overview the Infectious Diseases Society of America (IDSA) and American Thoracic Society (ATS) update to the Adult Community-Acquired Pneumonia (CAP) guidelines, with a focus on medications.
After 12 long years, the highly anticipated update to the CAP guidelines has arrived!
Continue reading “The New Community-Acquired Pneumonia Guidelines are Finally Here!”Antibiotics or Antidotes?
Predicting Failure of Outpatient Oral Antibiotics for Cellulitis

Uncomplicated Cellulitis? Consider Strep-only Coverage
Back in 2013, Dr. Pallin’s group in Boston published a study comparing clinical cure rates in uncomplicated cellulitis patients receiving cephalexin or cephalexin plus sulfamethoxazole-trimethoprim (SMX-TMP). I covered this study in a UMEM pearl, with the end result suggesting there was no difference in cure rate between the two treatment arms. Even in communities with high prevalence of MRSA, uncomplicated cellulitis cases without pus or abscess generally seem to be strep species. This was confirmed in the 2014 IDSA guidelines on SSTI in which they recommended streptococcal-only coverage for uncomplicated cases. A new study in JAMA reexamines this treatment strategy.
Continue reading “Uncomplicated Cellulitis? Consider Strep-only Coverage”
Importance of Second Antibiotic Doses in ED Sepsis Patients
Most studies evaluating early antibiotic administration in sepsis patients focus on timing of the first dose. We highlight many of these studies in our recent review article on Appropriate Antibiotic Therapy in Emergency Medicine Clinics of North America. But, what about the second dose? A new study in Critical Care Medicine asks that question. Specifically, what is the frequency and magnitude of delays in second dose in patients admitted from the Emergency Department AND what are the risk factors for these delays?
Continue reading “Importance of Second Antibiotic Doses in ED Sepsis Patients”